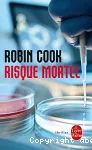
Risque mortel

Détail de l'auteur
Auteur Robin Cook |
Documents disponibles écrits par cet auteur (10)
 Ajouter le résultat dans votre panier Faire une suggestion Affiner la recherche Interroger des sources externes
Ajouter le résultat dans votre panier Faire une suggestion Affiner la recherche Interroger des sources externes
texte imprimé
Robin Cook, Auteur ; Nicole Hibert, Traducteur | Librairie générale française | Le Livre de poche, ISSN 0248-3653 | 2008Un homme de vingt-huit ans, dont la jambe est fracturée; une femme de trente-six ans qui souffre d'une rupture de ligaments. Tous deux morts dans les trente-quatre heures. Terreur à l'Hôpital général de Manhattan: des patients, pour la plupart j[...]
texte imprimé
Los Angeles. Dans un centre médical, huit personnes meurent : le directeur et 7 patients, emportés par un virus inconnu. Le CDS, organisme spécialisé dans le combat contre les maladies contagieuses, confie l'enquête à l'un de ses médecins, Maris[...]
texte imprimé
Robin Cook, Auteur ; Marie-France Girod, Traducteur | Librairie générale française | Le Livre de poche, ISSN 0248-3653 | DL 200445000 dollars en échange de quelques ovules : l'annonce passée par une clinique bostonienne a de quoi séduire. Deborah et Joanna, deux étudiantes fauchées, acceptent de se prêter à cette expérience censée remédier à la stérilité de certaines fem[...]
texte imprimé
Pourquoi les patients du docteur Jason Howard meurent-ils quelques semaines après un examen médical qui n'a rien décelé d'anormal ? Les autopsies ne révèlent aucun virus, mais un vieillissement soudain, brutal, des sujets...
texte imprimé
Le CHU Hobson, à New-York, n'est en rien différent des autres hôpitaux. Sauf que des jeunes femmes, après de banals examens gynécologiques, y sont victimes d'étranges vertiges qui s'accompagnent d'anomalies cérébrales inexplicables, repérables s[...]
texte imprimé
Brillant étudiant en informatique, Beau se blesse au doigt en ramassant un mystérieux petit disque de métal noir. Il ressent une forte fièvre et manifeste les symptômes d'une grippe carabinée, puis tout rentre dans l'ordre. Rétabli, il semble pl[...]
texte imprimé
Apprenant qu'elle est enceinte, la jeune danseuse Jénnifer éprouve des sentiments mitigés et son mari Adam plus encore. A la veille d'une brillante carrière médicale, il doit abandonner ses études et entrer à la compagnie pharmaceutique Arolen. [...]
texte imprimé
Edward Armstrong, brillant chercheur spécialisé dans les médicaments psychotropes, parvient à surmonter sa timidité pour séduire Kimberly Stewart, une jeune infirmière. Celle-ci est une descendante directe d'une des célèbres sorcières de Salem, [...]
texte imprimé
Helen, une jeune fille de vingt ans, est atteinte d'un cancer du cerveau en phase terminale. Un seul espoir : l'institut Forbes à Miami où des rémissions spectaculaires ont été obtenues. Au même moment, Sean Murphy, un jeune chercheur en biologi[...]
texte imprimé
Lorsqu'Erica Baron, jeune égyptologue fraîchement émoulue de harvard, arrive au Caire, elle n'a qu'une idée en tête : retrouver dans la vallée des Rois la tombe - inviolée - du mystérieux pharaon Séthi 1er. Mais une autre Egypte va la cerner, un[...]

